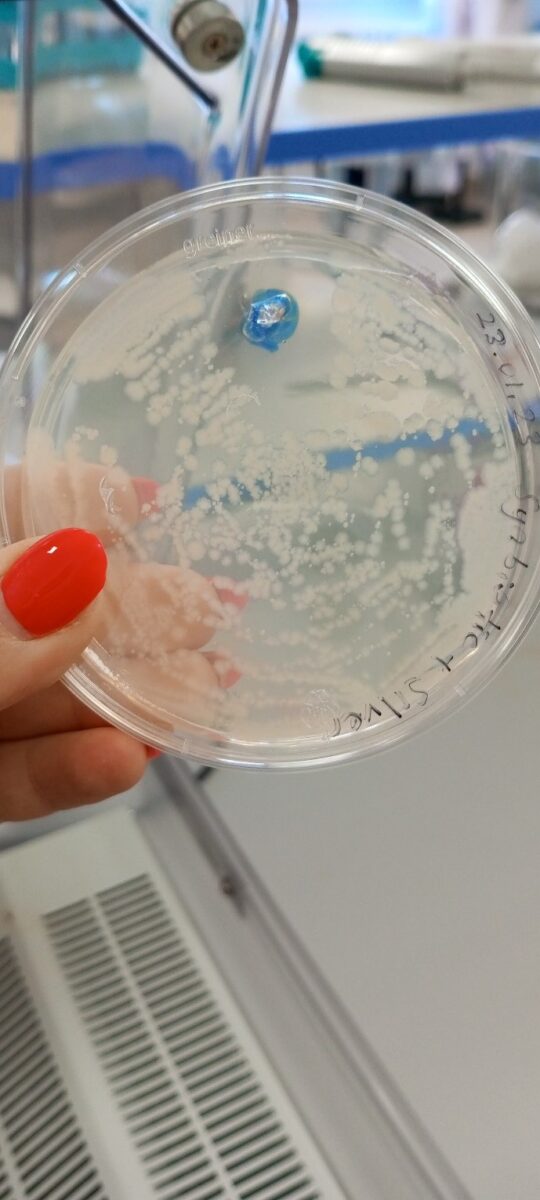

CT Biotech is actively conducting R&D activities and developing solutions for large-scale problems that impact daily life. Images below provide a compilation of some of the projects we are currently working on.

Antibacterial agent production


Development of suitable culture media for probiotic bacteria

Diagnosis Kits in Development


